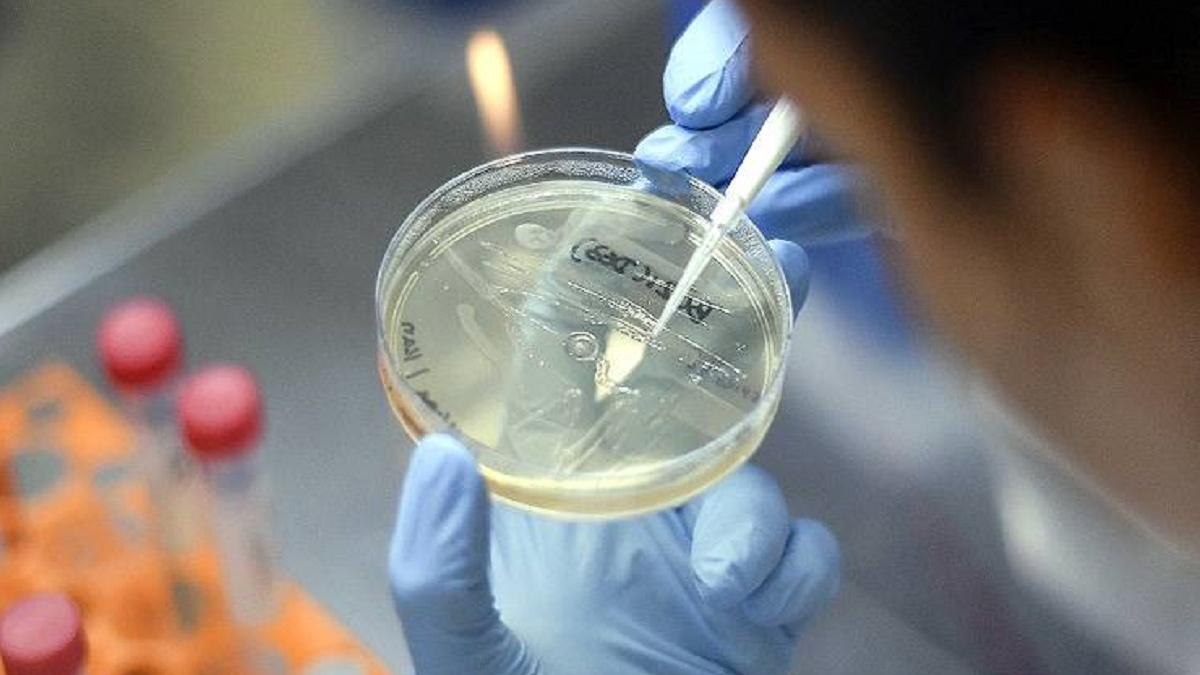
कोरोना के बाद जैविक खतरों के मुद्दों पर ध्यान (File Photo)

कोरोना वायरस: दुनिया को तैयार करना होगा जैव सुरक्षा फ्रेमवर्क
'कोरोना के बाद जैविक खतरों के मुद्दों को बारीकी से देखना होगा और एक जैव सुरक्षा फ्रेमवर्क तैयार करना होगा जो सार्वजनिक स्वास्थ्य हस्तक्षेपों की पूरी श्रृंखला को कवर करेगा'
Advertisement
X
स्टोरी हाइलाइट्स
- कोरोना वायरस के बाद के खतरों पर रिसर्च
- जैव सुरक्षा फ्रेमवर्क पर विशेषज्ञ का जोर
- कोरोना के बाद जैविक खतरों के मुद्दों पर ध्यान
कोरोना का कहर अभी भी जारी है. दुनिया भर के देश इस पर रिसर्च कर रहे हैं और कई देश वैक्सीन पर काम कर रहे हैं. भारत में भी इससे जुड़ी कई सारी रिसर्च चल रही हैं. इसी बीच विशेषज्ञ इस बात पर जोर दे रहे हैं कि विश्व को अब एक प्रभावी जैव सुरक्षा फ्रेमवर्क तैयार करना होगा जिससे भविष्य में जैविक खतरों से जुड़े मुद्दों को बारीकी से देखा जा सके.
दरअसल, विकासशील देशों की अनुसंधान एवं सूचना प्रणाली (आरआईएस) के महानिदेशक डॉ सचिन चतुर्वेदी के अनुसार कोरोना के बाद जैविक खतरों के मुद्दों को बारीकी से देखना होगा और एक जैव सुरक्षा फ्रेमवर्क तैयार करना होगा जो सार्वजनिक स्वास्थ्य हस्तक्षेपों की पूरी श्रृंखला को कवर करेगा.
उनका मानना है कि इस फ्रेमवर्क में वैज्ञानिक अनुसंधान, प्रारंभिक चेतावनी, नीति निर्माण, कार्यान्वयन, मूल्यांकन और जैव आपदा से मजबूती से निपटने की क्षमता तैयार करना शामिल होगा. इसके अलावा जैविक युद्ध के लिए राष्ट्रीय स्तर पर तैयारियों की मदद करने के लिए बायोसाइंस विशेषज्ञता और ज्ञान नेटवर्क को तत्काल विकसित करना होगा.
उन्होंने कहा कि भारत ने 26 मार्च 2020 को जैविक हथियार सम्मेलन (बीडब्ल्यूसी) को अधिक प्रभावी बनाने के लिए इसके संस्थागत ढांचे को अधिक से अधिक मजबूत बनाने का आह्वान किया. इसके अलावा, भारत ने पिछले कई वर्षों में लगातार एसटीआई और निरस्त्रीकरण के मुद्दे को उठाया है. कई विकासशील देशों ने भारत का समर्थन किया.
Advertisement
अमेरिका के सीनेटर क्रिस फोर्ड ने ट्वीट किया कि हम बीडब्ल्यूसी पर हस्ताक्षर करने वाले देशों की प्रतिबद्धताओं के महत्व पर बल देते हैं. फोर्ड यूएस स्टेट डिपार्टमेंट, ब्यूरो ऑफ इंटरनेशनल सिक्योरिटी एंड नॉन-प्रोलिफरेशन (आईएसएन) के सहायक सचिव भी हैं.
ये भी पढ़ें
- कोरोना से बीमार हॉस्पिटल में भर्ती ट्रंप बोले- अगले कुछ दिन 'असल परीक्षा' वाले
- जिस अस्पताल में चल रहा है ट्रंप का इलाज, उसके बाहर संदिग्ध बैग मिलने से हड़कंप





